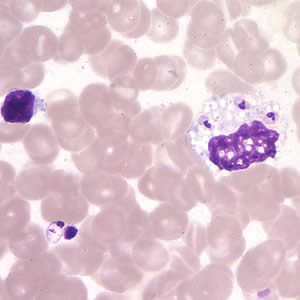
Case200_B.jpg

Case #200 – March, 2007
Approximately one and a half months after a trip to Costa Rica, a man developed a papule on the back of his right hand. The papule progressed to a 2 cm ulcer with a raised border. The ulcer was not tender but was draining serous fluid, and the surrounding skin was red and swollen. A second, similar eruption occurred on the same hand, and the man sought medical attention. His physician gathered clinical and travel history, examined the lesions, and contacted the Division of Parasitic Diseases for assistance. Tissue scrapings and a punch biopsy were collected. Suspicious objects were reported by the pathologists who reviewed the slides. Specimens were sent to DPD’s reference diagnostic laboratory for review. Figures A-C, taken at 1000× magnification, show what was seen on a Giemsa stained smear of a tissue scraping. What is your diagnosis? Based on what criteria? What other testing, if any, is indicated?

Figure A
Figure B

Figure C
Images presented in the DPDx case studies are from specimens submitted for diagnosis or archiving. On rare occasions, clinical histories given may be partly fictitious.
DPDx is an educational resource designed for health professionals and laboratory scientists. For an overview including prevention, control, and treatment visit www.cdc.gov/parasites/.